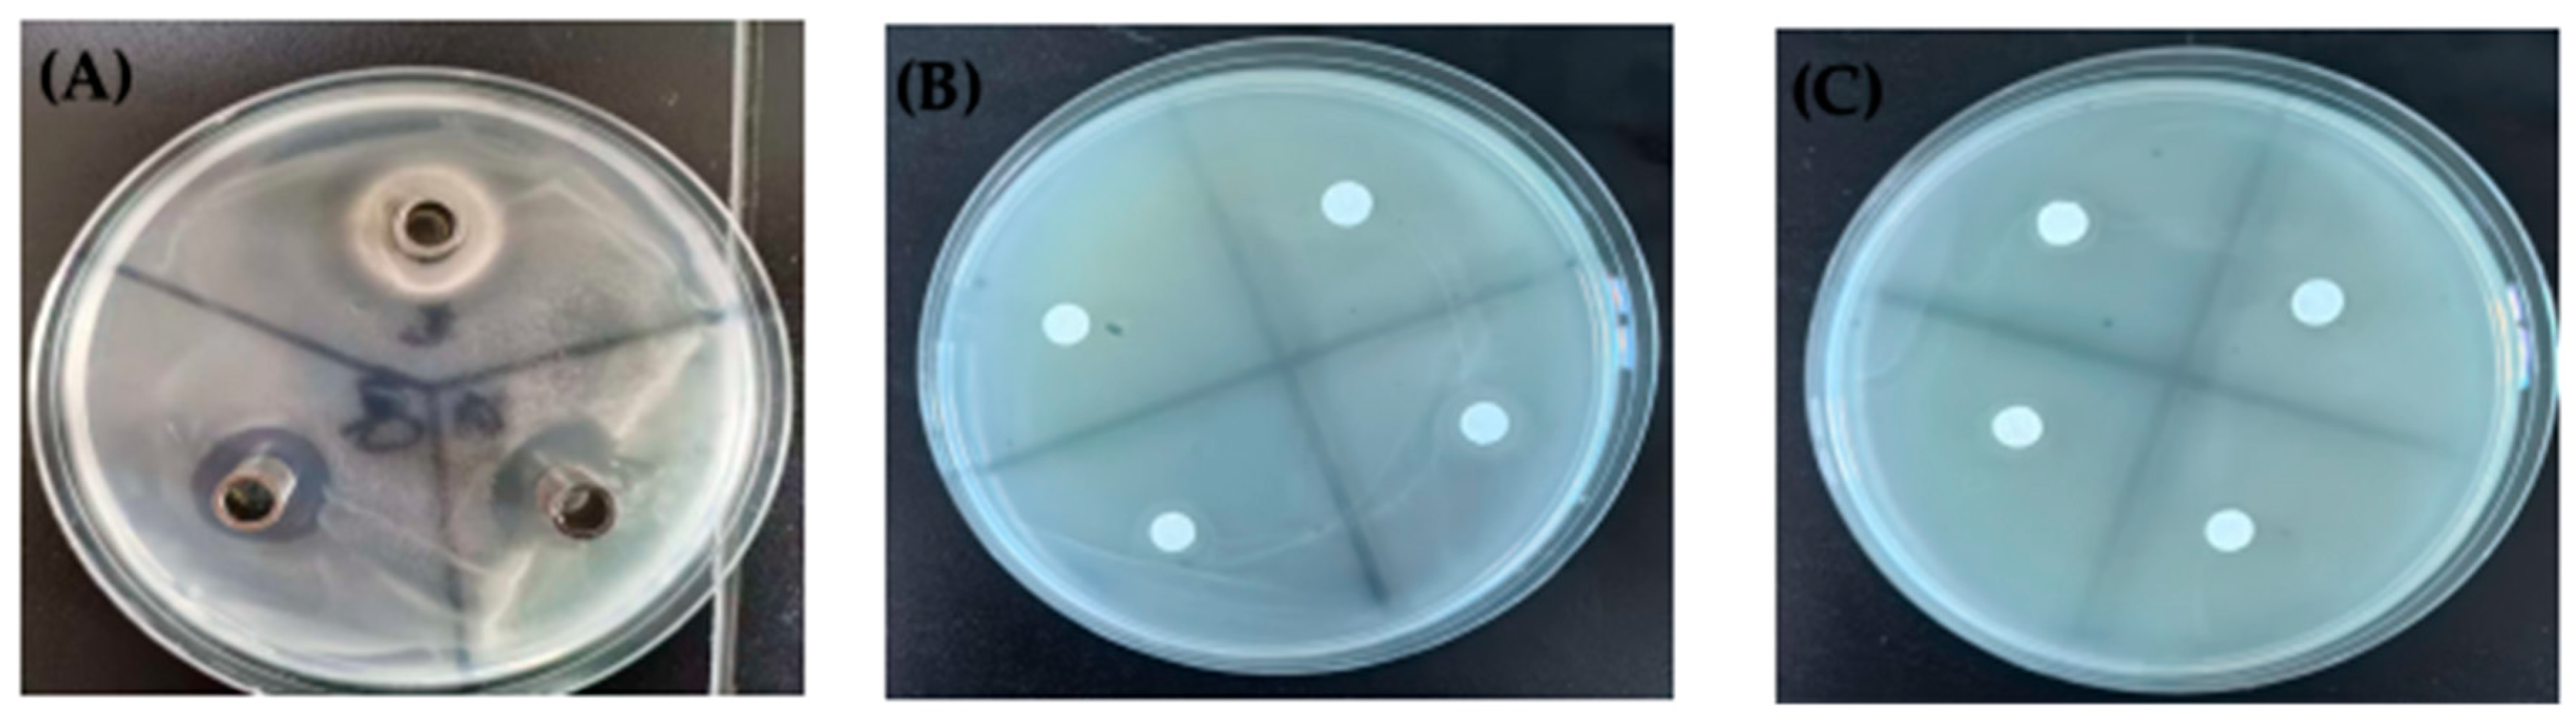
Fishes 10 00046 g003

Mitigating Vibrio-Induced Skin Ulceration in Sea Cucumbers Using Probiotic Strains
Abstract
1. Introduction
2. Materials and Methods
2.1. Experimental Chemicals and Sources
2.2. Isolation and Identification of Pathogenic Bacteria and Probiotic Bacteria
2.3. Transmission Electron Microscopy Observation of Pathogenic Bacteria
2.4. Antibacterial and Antagonistic Activity of Probiotics
2.5. Acute Challenge of Sea Cucumbers with Probiotics and Vibrio alginolyticus
2.6. Probiotic Feeding and Challenge Experiments
2.7. Statistical Analysis
2.8. Ethics Statement
3. Results
3.1. Isolation and Identification of Pathogenic Bacteria
3.2. Isolation and Molecular Identification of Probiotics
3.3. Antibacterial Activity and Compatibility of Probiotics
3.4. Biological Properties of Probiotics
3.5. Experimental Results of Acute Challenge of Sea Cucumbers with Probiotics and Vibrio alginolyticus
3.6. Probiotic Feeding Experiment
3.7. Post-Feeding Challenge Experiment
4. Discussion
5. Conclusions
Author Contributions
Funding
Institutional Review Board Statement
Informed Consent Statement
Data Availability Statement
Conflicts of Interest
References
- Ding, P.; Yu, Y.; Zhao, Z.; Li, X.; Wang, X.; Wang, H.; Huang, X.; Ding, J.; Zhao, C. Behavior, Intestinal Health, and Growth of Small Sea Cucumbers Apostichopus Japonicus in Different Color Morphs. Mar. Environ. Res. 2024, 193, 106300. [Google Scholar] [CrossRef] [PubMed]
- Sweet, M.J.; Bateman, K.S. Reprint of “Diseases in Marine Invertebrates Associated with Mariculture and Commercial Fisheries”. J. Sea Res. 2016, 113, 28–44. [Google Scholar] [CrossRef] [PubMed]
- Cánovas, F.; Domínguez-Godino, J.A.; González-Wangüemert, M. Epidemiology of Skin Ulceration Disease in Wild Sea Cucumber Holothuria Arguinensis, a New Aquaculture Target Species. Dis. Aquat. Organ. 2019, 135, 77–88. [Google Scholar] [CrossRef] [PubMed]
- Becker, P.; Gillan, D.; Lanterbecq, D.; Jangoux, M.; Rasolofonirina, R.; Rakotovao, J.; Eeckhaut, I. The Skin Ulceration Disease in Cultivated Juveniles of Holothuria Scabra (Holothuroidea, Echinodermata). Aquaculture 2004, 242, 13–30. [Google Scholar] [CrossRef]
- Liang, W.; Zhang, W.; Li, C. Vibrio Splendidus Virulence to Apostichopus Japonicus Is Mediated by HppD through Glutamate Metabolism and Flagellum Assembly. Virulence 2022, 13, 458–470. [Google Scholar] [CrossRef]
- Sampaio, A.; Silva, V.; Poeta, P.; Aonofriesei, F. Vibrio Spp.: Life Strategies, Ecology, and Risks in a Changing Environment. Diversity 2022, 14, 97. [Google Scholar] [CrossRef]
- Liu, H.; Zheng, F.; Sun, X.; Hong, X.; Dong, S.; Wang, B.; Tang, X.; Wang, Y. Identification of the Pathogens Associated with Skin Ulceration and Peristome Tumescence in Cultured Sea Cucumbers Apostichopus Japonicus (Selenka). J. Invertebr. Pathol. 2010, 105, 236–242. [Google Scholar] [CrossRef]
- Pang, H.; Zhang, W.; Lin, X.; Zeng, F.; Xiao, X.; Wei, Z.; Wang, S.; Jian, J.; Wang, N.; Li, W. Vibrio Alginolyticus PEPCK Mediates Florfenicol Resistance through Lysine Succinylation Modification. J. Proteome Res. 2024, 23, 2397–2407. [Google Scholar] [CrossRef]
- Zhao, Y.; Liu, H.; Wang, Q.; Li, B. The Influence of Three Antibiotics on the Growth, Intestinal Enzyme Activities, and Immune Response of the Juvenile Sea Cucumber Apostichopus Japonicus Selenka. Fish Shellfish Immunol. 2019, 84, 434–440. [Google Scholar] [CrossRef]
- Elvevoll, E.O.; James, D.; Toppe, J.; Gamarro, E.G.; Jensen, I.J. Food Safety Risks Posed by Heavy Metals and Persistent Organic Pollutants (POPs) Related to Consumption of Sea Cucumbers. Foods 2022, 11, 3992. [Google Scholar] [CrossRef]
- Denev, S.; Staykov, Y.; Moutafchieva, R.; Beev, G. International Aquatic Research Microbial Ecology of the Gastrointestinal Tract of Fish and the Potential Application of Probiotics and Prebiotics in Finfish Aquaculture. Int. Aquat. Res. Int Aquat Res 2009, 1, 1–29. [Google Scholar]
- Wang, A.; Ran, C.; Wang, Y.; Zhang, Z.; Ding, Q.; Yang, Y.; Olsen, R.E.; Ringø, E.; Bindelle, J.; Zhou, Z. Use of Probiotics in Aquaculture of China—A Review of the Past Decade. Fish Shellfish Immunol. 2019, 86, 734–755. [Google Scholar] [CrossRef]
- Raheem, A.; Liang, L.; Zhang, G.; Cui, S. Modulatory Effects of Probiotics During Pathogenic Infections With Emphasis on Immune Regulation. Front. Immunol. 2021, 12, 616713. [Google Scholar] [CrossRef] [PubMed]
- Shadrack, R.S.; Kotra, K.K.; Gereva, S.; Teiba, I.I.; El-Ratel, I.T.; El Basuini, M.F. Utilizing Dietary Probiotics Can Boost Amberjack (Seriola Dumerili) Lysozyme Activity, Antioxidant Capacity, and Gut Microbiota. Sci. Afr. 2023, 22, e01905. [Google Scholar] [CrossRef]
- Murtaza, B.; Jin, B.; Wang, L.; Li, X.; Kashif, M.; Majeed, S.; Khatoon, A.; Li, G.; Xu, Y. Mitigation of Zearalenone in Vitro Using Probiotic Strains. LWT 2023, 186, 115265. [Google Scholar] [CrossRef]
- Murtaza, B.; Li, X.; Dong, L.; Kashif, M.; Iqbal, M.; Majeed, S.; Ali, A.; Li, G.; Jin, B.; Wang, L.; et al. Toxicon In-Vitro Assessment of a Novel Plant Rhizobacterium, Citrobacter Freundii, for Degrading and Biocontrol of Food Mycotoxin Deoxynivalenol. Toxicon 2023, 227, 107095. [Google Scholar] [CrossRef] [PubMed]
- Marrie, T.J.; Noble, M.A.; Costerton, J.W. Examination of the Morphology of Bacteria Adhering to Peritoneal Dialysis Catheters by Scanning and Transmission Electron Microscopy. J. Clin. Microbiol. 1983, 18, 1388–1398. [Google Scholar] [CrossRef] [PubMed]
- Zhao, Y.; Yuan, L.; Wan, J.; Sun, Z.; Wang, Y.; Sun, H. Effects of Potential Probiotic Bacillus Cereus EN25 on Growth, Immunity and Disease Resistance of Juvenile Sea Cucumber Apostichopus Japonicus. Fish Shellfish Immunol. 2016, 49, 237–242. [Google Scholar] [CrossRef]
- Cai, L. High Cell Density Cultivation of Soybean Endophyte Bacillus and Preparation and Evaluation of Freeze-Dried Bacterial Power. Master’s Thesis. Hebei Agricultural University: Baoding, China, 2020. Available online: https://link.cnki.net/doi/10.27109/d.cnki.ghbnu.2020.000468 (accessed on 22 January 2025).
- Zhang, J.; Cao, Z.; Li, Z.; Wang, L.; Li, H.; Wu, F.; Jin, L.; Li, X.; Li, S.; Xu, Y. Effect of Bacteriophages on Vibrio Alginolyticus Infection in the Sea Cucumber, Apostichopus Japonicus (Selenka). J. World Aquac. Soc. 2015, 46, 149–158. [Google Scholar] [CrossRef]
- Li, Y.; Wang, Z.; Zheng, F.; Wang, B.; Liu, H.; Zhang, P.; Xin, M. Identification and Characterization of the Pathogen Associated with Skin Ulcer Syndrome in Lined Seahorse, Hippocampus Erectus. Aquac. Res. 2020, 51, 989–999. [Google Scholar] [CrossRef]
- Li, G.; Wang, M.Y. The Role of Vibrio Vulnificus Virulence Factors and Regulators in Its Infection-Induced Sepsis. Folia Microbiol. 2020, 65, 265–274. [Google Scholar] [CrossRef] [PubMed]
- Chatterjee, S.; More, M. Cyanobacterial Harmful Algal Bloom Toxin Microcystin and Increased Vibrio Occurrence as Climate-Change-Induced Biological Co-Stressors: Exposure and Disease Outcomes via Their Interaction with Gut–Liver–Brain Axis. Toxins 2023, 15, 289. [Google Scholar] [CrossRef] [PubMed]
- Wang, X.; Zhang, P.; Zhang, X. Probiotics Regulate Gut Microbiota: An Effective Method to Improve Immunity. Molecules 2021, 26, 6076. [Google Scholar] [CrossRef]
- Balcázar, J.L.; de Blas, I.; Ruiz-Zarzuela, I.; Cunningham, D.; Vendrell, D.; Múzquiz, J.L. The Role of Probiotics in Aquaculture. Vet. Microbiol. 2006, 114, 173–186. [Google Scholar] [CrossRef] [PubMed]
- Toledo, A.; Frizzo, L.; Signorini, M.; Bossier, P.; Arenal, A. Impact of Probiotics on Growth Performance and Shrimp Survival: A Meta-Analysis. Aquaculture 2019, 500, 196–205. [Google Scholar] [CrossRef]
- Rengpipat, S.; Rukpratanporn, S.; Piyatiratitivorakul, S.; Menasaveta, P. Immunity Enhancement in Black Tiger Shrimp (Penaeus Monodon) by a Probiont Bacterium (Bacillus S11). Aquaculture 2000, 191, 271–288. [Google Scholar] [CrossRef]
- Wang, Y.C.; Hu, S.Y.; Chiu, C.S.; Liu, C.H. Multiple-Strain Probiotics Appear to Be More Effective in Improving the Growth Performance and Health Status of White Shrimp, Litopenaeus Vannamei, than Single Probiotic Strains. Fish Shellfish Immunol. 2019, 84, 1050–1058. [Google Scholar] [CrossRef] [PubMed]
- Tinyiro, S.E.; Wokadala, C.; Xu, D.; Yao, W. Adsorption and Degradation of Zearalenone by Bacillus Strains. Folia Microbiol. 2011, 56, 321–327. [Google Scholar] [CrossRef] [PubMed]
- Zhang, Y.; Gao, C.; Dong, Y.; Chen, A. Prevention and treatment effect of Bacillus atrophicum CY1 on potato scab and its inhibitory mechanism. J. Anhui Polytech. Univ. 2024, 39, 9–15. [Google Scholar]
- Nakayama, T.; Lu, H.; Nomura, N. Inhibitory effects of Bacillus probionts on growth and toxin production of Vibrio harveyi pathogens of shrimp. Lett. Appl. Microbiol. 2009, 49, 679–684. [Google Scholar] [CrossRef]
- Jiang, N. Isolation, Identification and Application of Bacillus antagonistic to Vibrio parahaemolyticus. Master’s Thesis, South China University of Technology, Guangzhou, China, 2023. [Google Scholar] [CrossRef]
- Farzanfar, A. The Use of Probiotics in Shrimp Aquaculture. FEMS Immunol. Med. Microbiol. 2006, 48, 149–158. [Google Scholar] [CrossRef]

| Group | Experimental Content |
|---|---|
| Group 1 | 1 mL YB-1 at 1 × 104 CFU/mL |
| Group 2 | 1 mL YB-1 at 1 × 106 CFU/mL |
| Group 3 | 1 mL YB-1 at 1 × 108 CFU/mL |
| Group 4 | 1 mL YB-2 at 1 × 104 CFU/mL |
| Group 5 | 1 mL YB-2 at 1 × 106 CFU/mL |
| Group 6 | 1 mL YB-2 at 1 × 108 CFU/mL |
| Group 7 | 1 mL of a mixture of YB-1 and YB-2 at 1 × 106 CFU/mL (1:1 volume ratio) |
| Group 8 | 1 mL of a mixture of YB-1 and YB-2 at 1 × 108 CFU/mL (1:1 volume ratio) |
| Group 9 | 1mL PBS |
| pH | 6 | 7 | 8 | 9 | 10 |
|---|---|---|---|---|---|
| YB-1 (107 CFU/mL) | 2.11 ± 0.16 b | 6.60 ± 0.23 a | 5.91 ± 0.54 a | 2.15 ± 0.27 b | 0.91 ± 0.03 c |
| YB-2 (107 CFU/mL) | 2.32 ± 0.33 b | 5.41 ± 0.91 a | 4.93 ± 0.74 a | 1.75 ± 0.11 b | 0.75 ± 0.07 c |
| Temperature (°C) | 10 | 20 | 30 | 40 | 50 |
| YB-1 (106 CFU/mL) | 4.51 ± 1.13 c | 66.63 ± 8.17 a | 66.01 ± 1.73 a | 52.11 ± 4.31 b | 0.02 ± 0.01 d |
| YB-2 (106 CFU/mL) | 4.71 ± 0.14 b | 73.44 ± 3.65 a | 74.32 ± 5.02 a | 70.81 ± 4.21 a | 0.05 ± 0.01 c |
| Bile salts (g/L) | 0 | 1 | 2 | 4 | 6 |
| YB-1 (107 CFU/mL) | 6.32 ± 0.65 a | 6.12 ± 0.11 a | 5.49 ± 0.01 b | 2.31 ± 0.74 c | 0.98 ± 0.03 d |
| YB-2 (107 CFU/mL) | 5.74 ± 0.64 a | 4.41 ± 0.14 b | 2.10 ± 0.64 c | 0.93 ± 0.11 d | 0.48 ± 0.16 d |
| Protease (g/L) | 0 | 1 | 2 | 4 | 6 |
| YB-1 (107 CFU/mL) | 6.69 ± 1.12 a | 6.12 ± 0.88 ab | 5.83 ± 0.65 b | 5.57 ± 0.41 b | 5.31 ± 0.61 b |
| YB-2 (107 CFU/mL) | 7.28 ± 0.65 a | 5.33 ± 0.97 b | 3.77 ± 0.32 c | 1.66 ± 0.02 d | 1.31 ± 0.15 d |
| Experimental Groups | Average Initial Weight/g | Average Final Weight/g | Specific Growth Rate/d |
|---|---|---|---|
| Group 1 | 4.38 ± 0.13 | 7.960 ± 0.03 | 0.625 ± 0.04 b |
| Group 2 | 5.35 ± 0.02 | 11.50 ± 0.25 | 0.979 ± 0.97 de |
| Group 3 | 4.20 ± 0.19 | 9.03 ± 0.09 | 0.804 ± 0.91 cd |
| Group 4 | 4.52 ± 0.20 | 7.92 ± 0.02 | 0.597 ± 0.05 b |
| Group 5 | 5.08 ± 0.05 | 10.84 ± 0.12 | 0.881 ± 0.10 d |
| Group 6 | 4.05 ± 0.15 | 8.38 ± 0.05 | 0.735 ± 0.07 c |
| Group 7 | 4.68 ± 0.18 | 11.50 ± 0.20 | 0.968 ± 0.67 d |
| Group 8 | 4.87 ± 0.14 | 10.78 ± 0.33 | 0.836 ± 0.77 cd |
| Group 9 | 5.12 ± 0.13 | 8.01 ± 0.13 | 0.493 ± 0.06 a |
Disclaimer/Publisher’s Note: The statements, opinions and data contained in all publications are solely those of the individual author(s) and contributor(s) and not of MDPI and/or the editor(s). MDPI and/or the editor(s) disclaim responsibility for any injury to people or property resulting from any ideas, methods, instructions or products referred to in the content. |
© 2025 by the authors. Licensee MDPI, Basel, Switzerland. This article is an open access article distributed under the terms and conditions of the Creative Commons Attribution (CC BY) license (https://creativecommons.org/licenses/by/4.0/).
Share and Cite
Zhang, W.; Che, J.; Sun, X.; Murtaza, B.; Zhang, C.; Li, X.; Wang, L.; Xu, Y. Mitigating Vibrio-Induced Skin Ulceration in Sea Cucumbers Using Probiotic Strains. Fishes 2025, 10, 46. https://doi.org/10.3390/fishes10020046
Zhang W, Che J, Sun X, Murtaza B, Zhang C, Li X, Wang L, Xu Y. Mitigating Vibrio-Induced Skin Ulceration in Sea Cucumbers Using Probiotic Strains. Fishes. 2025; 10(2):46. https://doi.org/10.3390/fishes10020046
Chicago/Turabian StyleZhang, Wan, Jian Che, Xiaowen Sun, Bilal Murtaza, Chenghao Zhang, Xiaoyu Li, Lili Wang, and Yongping Xu. 2025. "Mitigating Vibrio-Induced Skin Ulceration in Sea Cucumbers Using Probiotic Strains" Fishes 10, no. 2: 46. https://doi.org/10.3390/fishes10020046
APA StyleZhang, W., Che, J., Sun, X., Murtaza, B., Zhang, C., Li, X., Wang, L., & Xu, Y. (2025). Mitigating Vibrio-Induced Skin Ulceration in Sea Cucumbers Using Probiotic Strains. Fishes, 10(2), 46. https://doi.org/10.3390/fishes10020046

